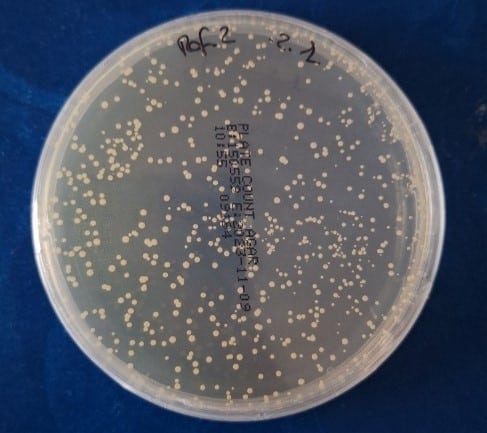
Placa de Petri con colonias bacterianas utilizada para evaluar la eficacia antimicrobiana de materiales durante ensayos microbiológicos

¿Cuál fue el reto o problema a resolver?
En determinados sectores industriales, la incorporación de materiales con propiedades antimicrobianas no puede basarse únicamente en declaraciones técnicas o ensayos preliminares. Cuando estos materiales deben operar en aplicaciones de elevada exigencia, resulta imprescindible validar su comportamiento real bajo condiciones representativas de uso.
En este contexto, el proyecto se centró en asegurar que la funcionalidad antimicrobiana se mantuviera estable a lo largo del tiempo y tras someter el material a diferentes solicitaciones mecánicas y ambientales.
Homologación de materiales en aplicaciones críticas
El punto de partida fue la necesidad de realizar una homologación de materiales destinados a entornos donde la carga microbiológica, la manipulación frecuente y las condiciones ambientales podían comprometer su rendimiento. En este tipo de aplicaciones, pequeños cambios en la superficie o en la composición pueden afectar significativamente a la eficacia antimicrobiana.
No bastaba con verificar la presencia de un aditivo o tratamiento superficial; era necesario demostrar que el conjunto del sistema mantenía su funcionalidad tras ciclos repetidos de uso, limpieza o exposición ambiental. El cliente requería garantías técnicas antes de validar el material para su integración definitiva en producto, ya que una validación insuficiente podía derivar en pérdida de prestaciones, reclamaciones o riesgos sanitarios.
La homologación debía sustentarse en datos cuantificables y comparables, alineados con criterios técnicos objetivos. El beneficio esperado era disponer de una decisión fundamentada que redujera incertidumbre en fases posteriores de industrialización.
Actividad antimicrobiana bajo condiciones exigentes
Uno de los aspectos clave fue evaluar la actividad antimicrobiana tras someter el material a distintos escenarios de estrés controlado. En muchos casos, los materiales antimicrobianos ofrecen resultados favorables en condiciones iniciales de laboratorio, pero su comportamiento puede verse afectado por desgaste superficial, migración de aditivos o degradación química.
El proyecto buscaba determinar si la eficacia antimicrobiana se mantenía dentro de los rangos aceptables tras el envejecimiento simulado. Para ello, se establecieron condiciones que representaban situaciones reales de uso acumulado, incluyendo exposición ambiental y ciclos repetitivos.
La eficacia antimicrobiana inicial no garantiza su estabilidad tras uso real: validar su durabilidad es clave para evitar fallos en servicio.
El objetivo no era únicamente confirmar una reducción microbiológica puntual, sino analizar la estabilidad de esa reducción en el tiempo. Esta visión permitió abordar la validación desde una perspectiva funcional y no únicamente declarativa, aportando mayor solidez técnica al proceso.
Ensayo acelerado como reto técnico
El principal desafío consistía en diseñar un ensayo acelerado capaz de reproducir en un periodo reducido los efectos acumulativos del uso prolongado. Esta fase exigía definir parámetros coherentes con la aplicación final, evitando tanto la infraestimación como la sobrerrepresentación de las condiciones reales.
La dificultad técnica radicaba en establecer ciclos de envejecimiento que permitieran anticipar posibles degradaciones sin alterar artificialmente el comportamiento del material. La representatividad de las condiciones aplicadas era crítica para que los resultados fueran extrapolables.
Un ensayo acelerado mal definido puede generar resultados no extrapolables y decisiones técnicas erróneas.
El equipo de INFINITIA definió los escenarios de solicitación y los criterios de aceptación, asegurando que la metodología combinara rigor científico y aplicabilidad industrial. Este enfoque permitió transformar una incertidumbre inicial en un proceso estructurado de evaluación objetiva.

¿Cómo se abordó o cuál fue la solución?
La solución se estructuró mediante una metodología progresiva que integraba simulación de uso, verificación microbiológica y análisis comparativo de resultados. El planteamiento técnico estuvo orientado a reducir riesgos antes de la implantación industrial y a garantizar coherencia entre condiciones de ensayo y entorno final de aplicación.
Ensayos a medida para validación funcional
Se diseñaron ensayos a medida adaptados específicamente al contexto de aplicación del material. Esta personalización permitió ajustar variables críticas como temperatura, humedad relativa, ciclos de manipulación o exposición a agentes externos, evitando aplicar protocolos estándar que no reflejaran la realidad operativa.
El enfoque contempló la caracterización inicial del material y su evaluación posterior tras las solicitaciones definidas. Esta comparativa permitió identificar posibles variaciones en el rendimiento antimicrobiano y analizar su relevancia técnica.
La estrategia de validación funcional no se limitó a un único escenario, sino que integró diferentes condiciones de estrés representativas. De este modo, la validación de materiales se apoyó en un marco experimental robusto y orientado a la toma de decisiones.
Ensayos microbiológicos y evaluación de prestaciones
La comprobación de la eficacia se realizó mediante ensayos microbiológicos que permitieron cuantificar la reducción de carga microbiana antes y después del envejecimiento simulado. Estos ensayos aportaron datos objetivos sobre la capacidad real del material para mantener su efecto antimicrobiano tras la exposición a condiciones exigentes.
Se utilizó E. Coli como microorganismo modelo, gracias a su amplio uso en estándares de evaluación antimicrobiana. Las muestras se sometieron a pruebas basadas en el método Japanese Industrial Standard JIS Z 2801, así como la ISO 22196:2011 o ISO 20743:2013.
La validación microbiológica cuantitativa permite diferenciar entre pérdida puntual de eficacia y degradación real del material.
Se analizaron las variaciones en la reducción microbiológica y se establecieron umbrales de aceptación alineados con los requisitos técnicos del cliente. Esta evaluación permitió diferenciar entre pérdida puntual de eficacia y degradación significativa del rendimiento.
El equipo de Ingeniería Forense de INFINITIA coordinó la ejecución experimental, el control de variables y la interpretación crítica de los resultados. La integración de datos cuantitativos con el contexto de aplicación permitió emitir conclusiones fundamentadas y técnicamente justificadas.
Beneficios de la homologación de materiales validada técnicamente
Como resultado, el cliente dispuso de una base técnica sólida para decidir sobre la viabilidad del material en su aplicación final. La combinación de ensayo acelerado, simulación de uso y verificación microbiológica permitió reducir incertidumbre y anticipar posibles desviaciones de rendimiento antes de la producción a gran escala.
La homologación de materiales se sustentó en evidencias experimentales reproducibles, lo que facilita su respaldo ante auditorías internas, exigencias normativas o procesos de certificación. Además, el estudio permitió identificar posibles ajustes de formulación o mejora de diseño antes de su implantación definitiva.
Este enfoque no solo valida una propiedad específica, sino que refuerza la fiabilidad global del producto en entornos de elevada exigencia, minimizando riesgos técnicos y económicos asociados a decisiones basadas únicamente en datos preliminares.